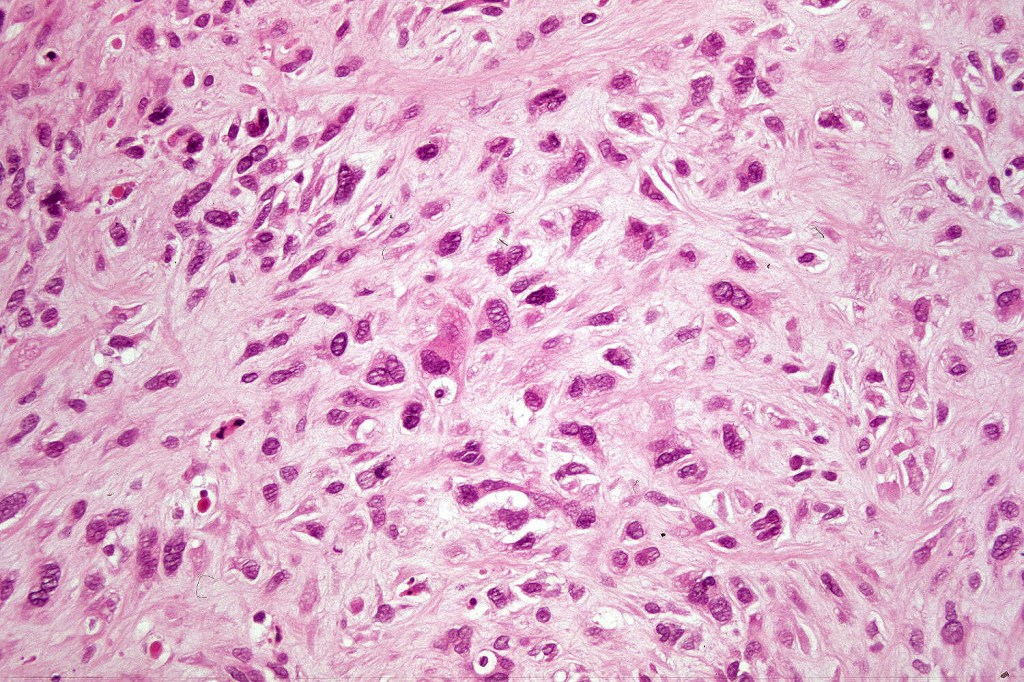
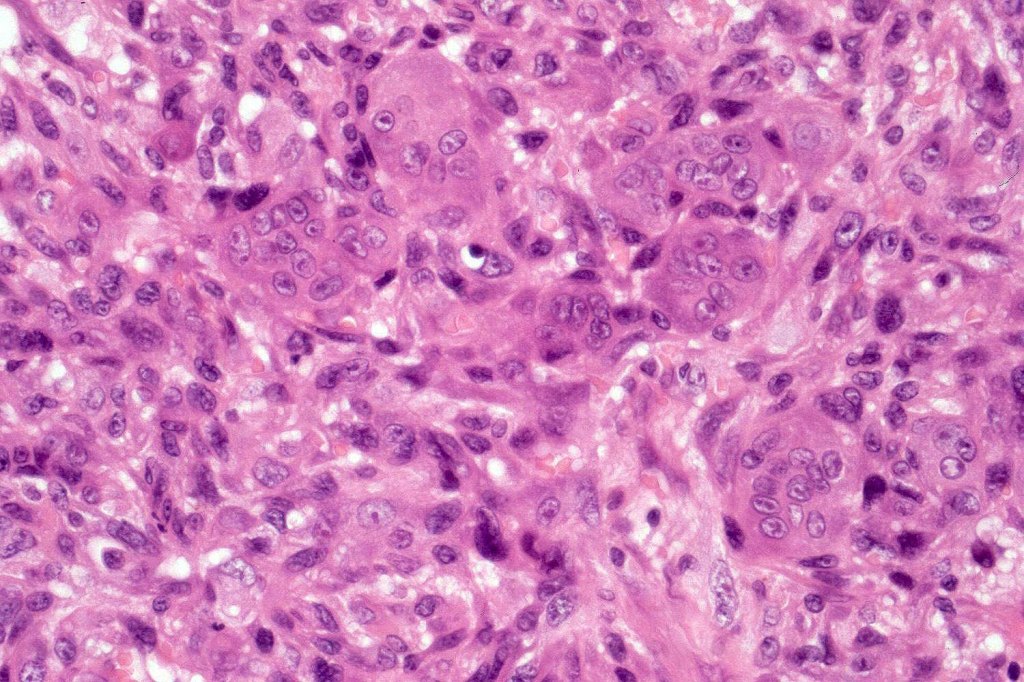
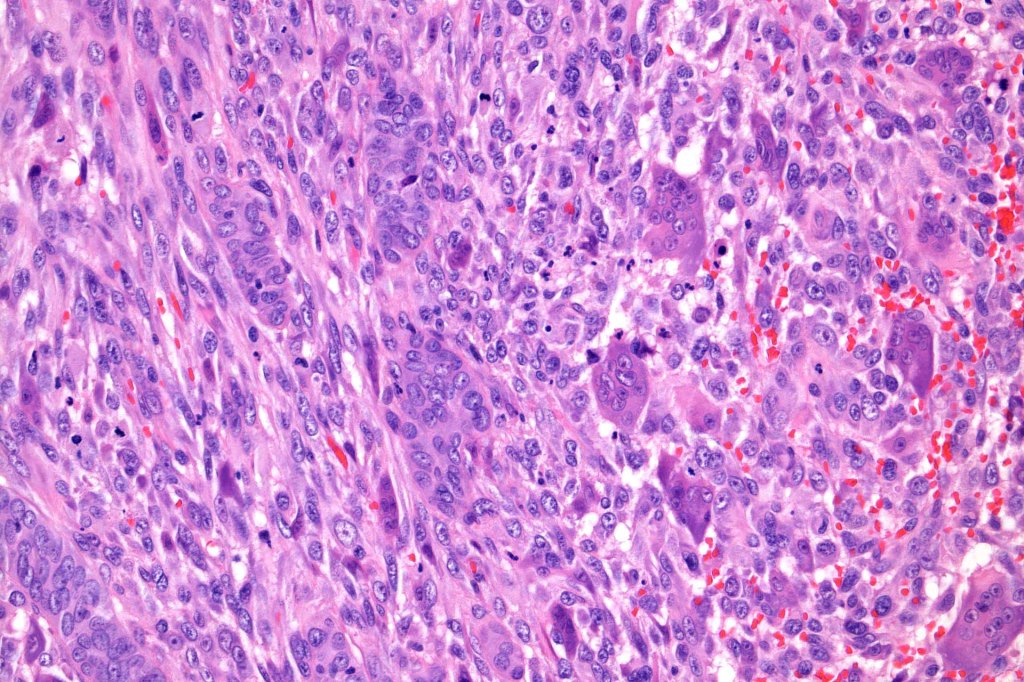
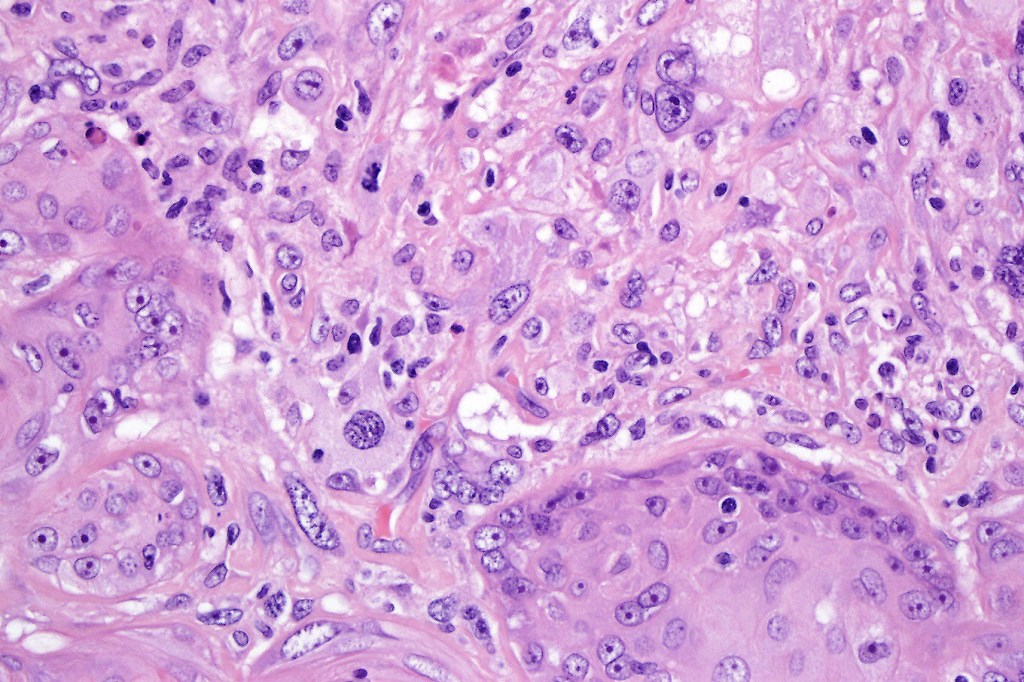
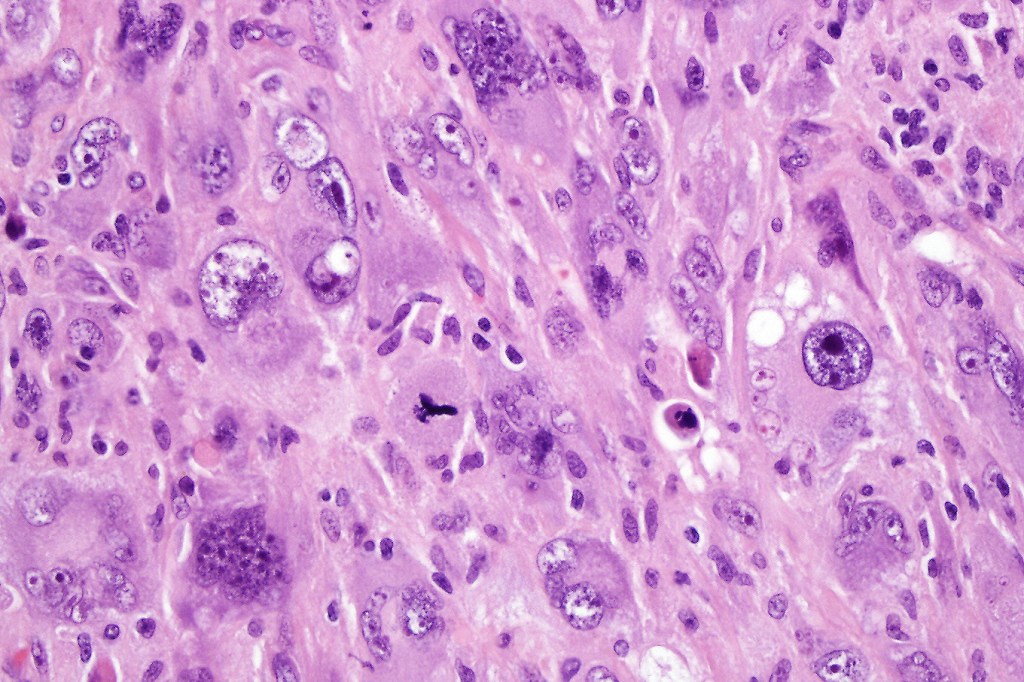
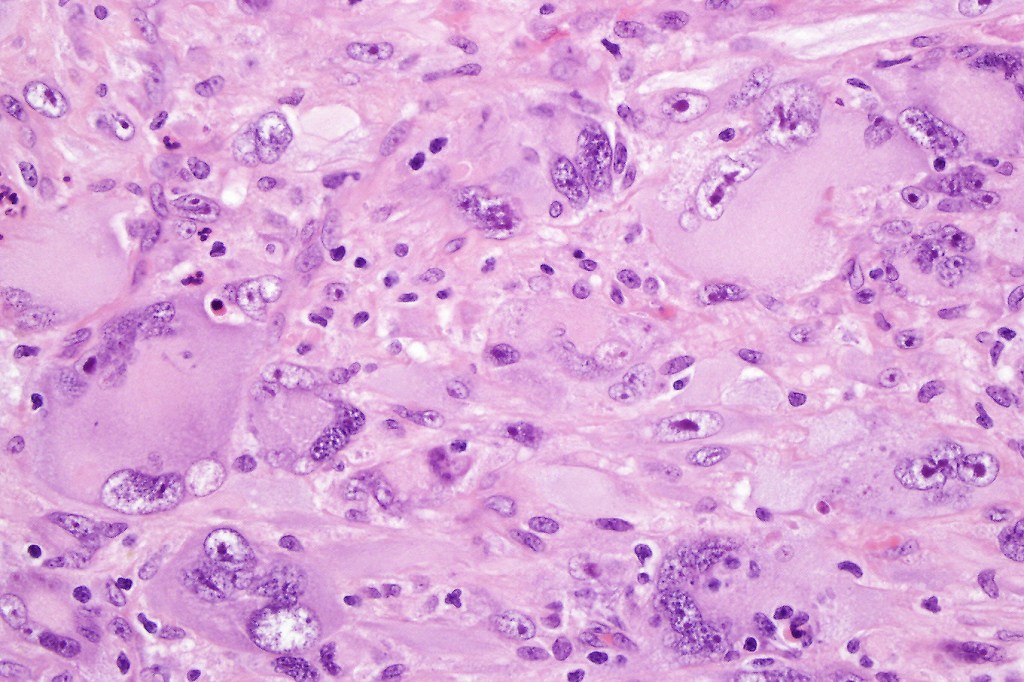

Cutaneous carcinosarcoma (metaplastic carcinoma, carcinoma with heterologous differentiation)
Clinical features
•Exceedingly rare
•May arise in the elderly in a pre-existent SCC or BCC (M>F mean age 72), relatively good prognosis
•May develop in a spiradenocarcinoma, malignant proliferating pilar tumor, matricial carcinoma, carcinoma ex chondroid syringoma or porocarcinoma (M=F, mean age 58 years), generally poor prognosis
Histological features
•Osteoid
•Chondroid
•Smooth muscle
•MFH-like features with osteoclasts
•Neural differentiation

Leave a comment